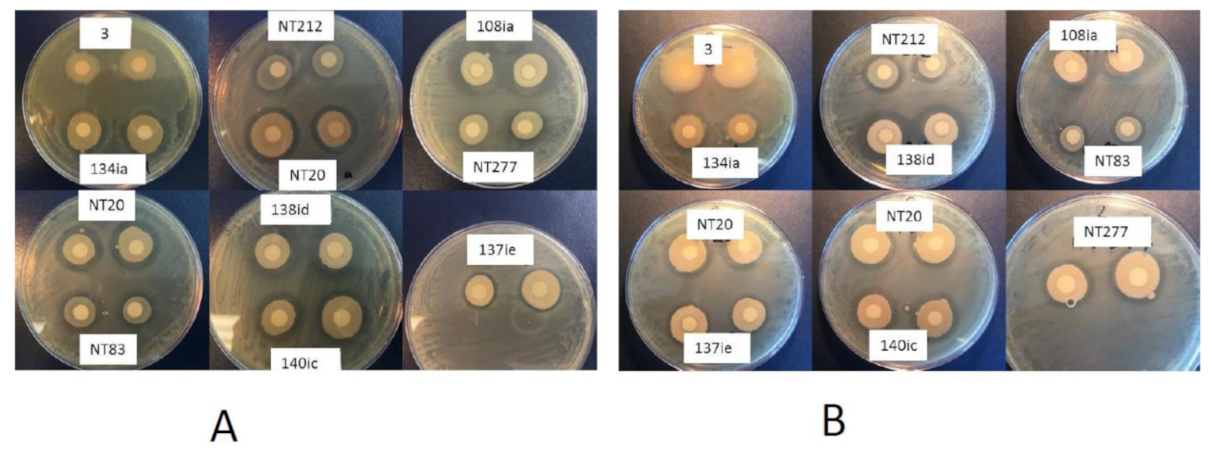
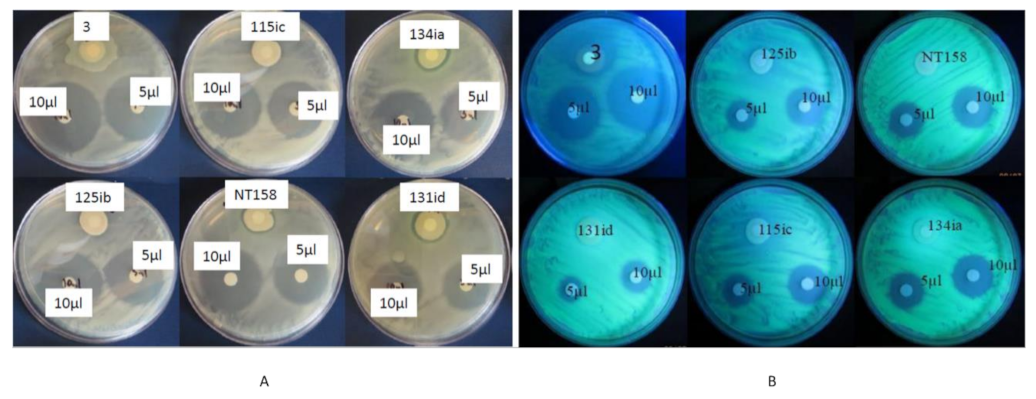

Soybean Nodule-Associated Non-Rhizobial Bacteria Inhibit Plant Pathogens and Induce Growth Promotion in Tomato
Abstract
1. Introduction
2. Results
2.1. Isolation of Soybean Nodule Bacteria
2.2. In Vitro Antibacterial and Antifungal Bioassay
2.3. In Vitro Metabolite Test
2.4. Identification of Bacterial Isolates
2.5. Identification of Bacterial Endophytes in One Soybean Nodule
2.6. In Vivo Seedling Test against Pseudomonas syringae pv. Tomato (Pst)
2.7. In Vivo Seedling Test against Clavibacter Michiganensis subsp. Michiganensis
3. Discussion
4. Materials and Methods
4.1. Isolation of Soybean Nodule Bacteria
4.1.1. Collection and Surface Sterilization of Nodules
4.1.2. Isolation of Bacteria from Surface-Sterilized Nodules
4.2. Plant Pathogenic Bacterial and Fungal Isolates
4.3. Identification of Selected Bacterial Isolates
4.4. Soybean Nodule Bacterial Community
4.5. In Vitro Screening of Potential Antagonistic Activity of Soybean Nodule-Associated Bacteria against Bacterial and Fungal Plant Pathogens
4.5.1. Preparation of Bacterial Pathogen Inoculum
4.5.2. Preparation of Antagonist Inoculums
4.5.3. In Vitro Antifungal Bioassay
4.6. In Vitro Screening of Metabolites
4.6.1. Extraction of Metabolites
4.6.2. In Vitro Metabolite Test
4.7. In Vivo Seedling Test
In Planta Test
4.8. Statistical Analysis
5. Conclusions
Author Contributions
Funding
Acknowledgments
Conflicts of Interest
References
- Philippot, L.; Raaijmakers, J.M.; Lemanceau, P.; Van Der Putten, W.H. Going back to the roots: The microbial ecology of the rhizosphere. Nat. Rev. Microbiol. 2013, 11, 789–799. [Google Scholar] [CrossRef] [PubMed]
- Haichar, F.Z.; Santaella, C.; Heulin, T.; Achouak, W. Root exudates mediated interactions belowground. Soil Biol. Biochem. 2014, 77, 69–80. [Google Scholar] [CrossRef]
- Bhattacharyya, P.N.; Jha, D.K. Plant growth-promoting rhizobacteria (PGPR): Emergence in agriculture. World J. Microbiol. Biotechnol. 2012, 28, 1327–1350. [Google Scholar] [CrossRef] [PubMed]
- Schultze, M.; Kondorosi, A. Regulation of symbiotic root nodule development. Annu. Rev. Genet. 1988, 32, 33–57. [Google Scholar] [CrossRef] [PubMed]
- Velázquez, E.; Carro, L.; Flores-Félix, J.D.; Menéndez, E.; Ramírez-Bahena, M.H.; Peix, A. Bacteria-Inducing Legume Nodules Involved in the Improvement of Plant Growth, Health and Nutrition. In Microbiome in Plant Health and Disease; Kumar, V., Prasad, R., Kumar, M., Choudhary, D., Eds.; Springer: Singapore, 2019; pp. 79–104. [Google Scholar]
- Ibáñez, F.; Tonelli, M.L.; Muñoz, V.; Figueredo, M.S.; Fabra, A. Bacterial Endophytes of Plants: Diversity, Invasion Mechanisms and Effects on the Host. In Endophytes: Biology and Biotechnology; Maheshwari, K.D., Ed.; Springer: Berlin/Heidelberg, Germany, 2017; pp. 25–40. [Google Scholar]
- Martínez-Hidalgo, P.; Hirsch, A.M. The nodule microbiome: N2-fixing rhizobia do not live alone. Phytobiomes J. 2017, 1, 1–13. [Google Scholar] [CrossRef]
- De Meyer, S.E.; De Beuf, K.; Vekeman, B.; Willems, A. A large diversity of non-rhizobial endophytes found in legume root nodules in Flanders (Belgium). Soil Biol. Biochem. 2015, 83, 1–11. [Google Scholar] [CrossRef]
- Velázquez, E.; Martínez-Hidalgo, P.; Carro, L.; Alonso, P.; Peix, A.; Trujillo, M.E.; Martínez-Molina, E. Nodular endophytes: An untapped diversity. In Beneficial Plant Microbial Interactions: Ecology and Applications; González, M.B.R., González-Lopez, J., Eds.; CRC Press: Boca Raton, FL, USA, 2013; pp. 215–236. [Google Scholar]
- Rajendran, G.; Patel, M.H.; Joshi, S.J. Isolation and characterization of nodule- associated Exiguobacterium sp. from the root nodules of fenugreek (Trigonella foenum-graecm) and their possible role in plant growth promotion. Int. J. Microbiol. 2012, 2012, 693982. [Google Scholar] [CrossRef]
- Beneduzi, A.; Ambrosini, A.; Passaglia, L.M.P. Plant growth-promoting rhizobacteria (PGPR): Their potential as antagonists and biocontrol agents. Genet. Mol. Biol. 2012, 35, 1044–1051. [Google Scholar] [CrossRef]
- Raaijmakers, J.M.; Paulitz, T.C.; Steinberg, C.; Alabouvette, C.; Moënne-Loccoz, Y. The rhizosphere: A playground and battlefield for soilborne pathogens and beneficial microorganisms. Plant Soil. 2009, 321, 341–361. [Google Scholar] [CrossRef]
- Doornbos, R.F.; van Loon, L.C.; Bakker, P.A.H.M. Impact of root exudates and plant defense signaling on bacterial communities in the rhizosphere. A review. Agron. Sustain. Dev. 2012, 32, 227–243. [Google Scholar] [CrossRef]
- Berendsen, R.L.; Pieterse, C.M.J.; Bakker, P.A.H.M. The rhizosphere microbiome and plant health. Trends Plant Sci. 2012, 17, 478–486. [Google Scholar] [CrossRef]
- Nega, A. Review on concepts in biological control of plant pathogens. J. Biol. Agri. Healthcare 2014, 4, 33–55. [Google Scholar]
- Pieterse, C.M.J.; Zamioudis, C.; Berendsen, R.L.; Weller, D.M.; Van Wees, S.C.M.; Bakker, P.A.H.M. Induced systemic resistance by beneficial microbes. Annu. Rev. Phytopathol. 2014, 52, 347–375. [Google Scholar] [CrossRef] [PubMed]
- Aserse, A.A.; Räsänen, L.A.; Aseffa, F.; Hailemariam, A.; Lindström, K. Diversity of sporadic symbionts and nonsymbiotic endophytic bacteria isolated from nodules of woody, shrub, and food legumes in Ethiopia. Appl. Microbiol. Biotechnol. 2013, 97, 10117–10134. [Google Scholar] [CrossRef] [PubMed]
- Goswami, D.; Thakker, J.N.; Dhandhukia, P.C. Portraying mechanics of plant growth promoting rhizobacteria (PGPR): A review. Cogent Food Agric. 2016, 2, 1–19. [Google Scholar] [CrossRef]
- Clúa, J.; Roda, C.; Zanetti, M.E.; Blanco, F.A. Compatibility between legumes and rhizobia for the establishment of a successful nitrogen-fixing symbiosis. Genes 2018, 9, 125. [Google Scholar] [CrossRef]
- Zhao, L.; Xu, Y.; XinHe, L. Antagonistic endophytic bacteria associated with nodules of soybean (Glycine max L.) and plant growth-promoting properties. Braz. J. Microbiol. 2018, 49, 269–278. [Google Scholar] [CrossRef] [PubMed]
- Li, J.H.; Wang, E.T.; Chen, W.F.; Chen, W.X. Genetic diversity and potential for promotion of plant growth detected in nodule endophytic bacteria of soybean grown in Heilongjiang province of China. Soil Biol. Biochem. 2008, 40, 238–246. [Google Scholar] [CrossRef]
- Inam-ul-Haq, M.; Javed, N.; Ahmad, R.; Rehman, A. Evaluation of different strains of pseudomonas fluorescens for the biocontrol of Fusarium wilt of Chickpea. Pak. J. Plant Pathol. 2003, 2, 65–74. [Google Scholar]
- Williams, G.E.; Asher, M.J.C. Selection of rhizobacteria for the control of Pythium ultimum and Aphanomyces cochlioides on sugar-beet seedlings. Crop Prot. 1996, 15, 479–486. [Google Scholar] [CrossRef]
- Pathma, J.; Rahul, G.R.; Kamaraj, K.R.; Subashri, R.; Sakthivel, N. Secondary metabolite production by bacterial antagonists. J. Biol. Control. 2011, 25, 165–181. [Google Scholar]
- Selin, C.; Habibian, R.; Poritsanos, N.; Athukorala, S.N.P.; Fernando, D.; De Kievit, T.R. Phenazines are not essential for Pseudomonas chlororaphis PA23 biocontrol of Sclerotinia sclerotiorum, but do play a role in biofilm formation. FEMS Microbiol. Ecol. 2010, 71, 73–83. [Google Scholar] [CrossRef]
- Zhao, L.; Wang, F.; Zhao, J. Identification and functional characteristics of chlorpyrifos-degrading and plant growth promoting bacterium Acinetobacter calcoaceticus. J. Basic Microbiol. 2014, 54, 457–463. [Google Scholar] [CrossRef] [PubMed]
- Maindad, D.V.; Kasture, V.M.; Chaudhari, H.; Dhavale, D.D.; Chopade, B.A.; Sachdev, D.P. Characterization and fungal inhibition activity of siderophore from wheat rhizosphere associated Acinetobacter calcoaceticus strain HIRFA32. Indian J. Microbiol. 2014, 54, 315–322. [Google Scholar] [CrossRef]
- Costa-Gutierrez, S.B.; Lami, M.J.; Santo, M.C.C.; Zenoff, A.M.; Vincent, P.A.; Molina-Henares, M.A.; Espinosa-Urgel, M.; de Cristóbal, R.E. Plant growth promotion by Pseudomonas putida KT2440 under saline stress: Role of eptA. Appl. Microbiol. Biotechnol. 2020, 104, 4577–4592. [Google Scholar] [CrossRef] [PubMed]
- Qessaoui, R.; Bouharroud, R.; Furze, J.N.; El Aalaoui, M.; Akroud, H.; Amarraque, A.; Van Vaerenbergh, J.; Tahzima, R.; Mayad, E.H.; Chebli, B. Applications of new rhizobacteria pseudomonas isolates in agroecology via fundamental processes complementing plant growth. Sci. Rep. 2019, 9, 12832. [Google Scholar] [CrossRef]
- Gano-Cohen, K.A.; Stokes, P.J.; Blanton, M.A.; Wendlandt, C.E.; Hollowell, A.C.; Regus, J.U.; Kim, D.; Patel, S.; Pahua, V.J.; Sachs, J.L. Nonnodulating Bradyrhizobium spp. modulate the benefits of legume-rhizobium mutualism. Appl. Environ. Microbiol. 2016, 82, 5259–5268. [Google Scholar] [CrossRef]
- Lanna Filho, R.; de Souza, R.M.; Ferreira, A.; Quecine, M.C.; Alves, E.; de Azevedo, J.L. Biocontrol activity of Bacillus against a GFP-marked Pseudomonas syringae pv. tomato on tomato phylloplane. Australas. Plant Pathol. 2013, 42, 643–651. [Google Scholar] [CrossRef][Green Version]
- Lakshman, D.K.; Roberts, D.P.; Garrett, W.M.; Natarajan, S.S.; Darwish, O.; Alkharouf, N.; Pain, A.; Khan, F.; Jambhulkar, P.P.; Mitra, A. Proteomic investigation of Rhizoctonia solani AG 4 identifies secretome and mycelial proteins with roles in plant cell wall degradation and virulence. J. Agric. Food Chem. 2016, 64, 3101–3110. [Google Scholar] [CrossRef]
- Loy, J.D.; Clawson, M.D. Rapid typing of Mannheimia haemolytica major genotypes 1 and 2 using MALDI-TOF mass spectrometry. J. Microbiol. Methods 2017, 136, 30–33. [Google Scholar] [CrossRef]
- R Core Team. R: A Language and Environment for Statistical Computing; R Foundation for Statistical Computing: Vienna, Austria, 2013; Available online: http://www.R-project.org/ (accessed on 28 September 2020).

| Sample ID | MALDI TOF MS Based ID | Score |
|---|---|---|
| 108 ia | Pseudomonas chlororaphis | 1.91 |
| 113 id | Pseudomonas cepacia | 1.97 |
| 115 ic | Pseudomonas chlororaphis | 1.93 |
| 134 ia | Pseudomonas putida | 2.32 |
| 138 id | Pseudomonas stutzeri | 1.96 |
| NT 21 | Enterobacter cloacae | 2.33 |
| NT 76 ia | Pseudomonas acidovorans | 2.36 |
| 108 ic | Pseudomonas chlororaphis | 2.12 |
| 140 ic | Pseudomonas fluorescens | 1.93 |
| NT 76 ie | Pseudomonas brassicacearum | 1.89 |
| 125 ib | Acinetobacter calcoaceticus | 1.84 |
| 3 | Proteus hauseri | 1.96 |
| NT 158 | Enterobacter cloacae | 2.40 |
| 131 id | Pseudomonas putida group | 1.98 |
| NT 88 | Ochrobactrum species | 1.97 |
| Sample ID | 16S Based ID | Closest Genbank Match (>99%) |
|---|---|---|
| 108 ia | Pseudomonas chlororaphis | NBAT01000000 |
| 113 id | Pseudomonas cepacia | CP011301 |
| 115 ic | Pseudomonas chlororaphis | NBAT01000000 |
| 134 ia | Pseudomonas putida | AP013070 |
| 138 id | Pseudomonas stutzeri | CP003071 |
| NT 21 | Enterobacter cloacae | EU733519 |
| NT 76 ia | Pseudomonas acidovorans | CP00884 |
| 108 ic | Pseudomonas chlororaphis | NBAT01000000 |
| 140 ic | Pseudomonas fluorescens | CP005975 |
| NT 76 ie | Pseudomonas brassicacearum | NHAS01000000 |
| 125 ib | Acinetobacter calcoaceticus | AB859067 |
| 3 | Proteus hauseri | CO5028 |
| NT 158 | Enterobacter cloacae | KJ668861 |
| 131 id | Pseudomonas species | |
| NT 88 | Ochrobactrum anthropi | AB778290 |
| Genus | Family | Order | Class |
|---|---|---|---|
| Agrobacterium spp. | Rhizobiaceae | Rhizobiales | Alphaproteobacteria |
| Ochrobactrum sp. | Brucellaceae | Rhizobiales | Alphaproteobacteria |
| Burkholderia spp. | Burkholderiaceae | Burkholderiales | Betaproteobacteria |
| Pseudomonas spp. | Pseudomonadaceae | Pseudomonadales | Gammaproteobacteria |
| Proteus spp. | Enterobacteriaceae | Enterobacteriales | Gammaproteobacteria |
| Enterobacter spp. | Enterobacteriaceae | Enterobacteriales | Gammaproteobacteria |
| Pantoea spp. | Enterobacteriaceae | Enterobacteriales | Gammaproteobacteria |
| Acinatobacter spp. | Moraxellaceae | Pseudomonadales | Gammaproteobacteria |
| Treatments | Shoot Height (cm) | Shoot Biomass (g) |
|---|---|---|
| Control | 50 ± 8.8 | 58.2 ± 17.2 |
| 115ic | 55.4 ± 7.9 * | 77.6 ± 29.3 ** |
| 3 | 54.1 ± 5.1 | 67.1 ± 37.2 |
| NT158 | 53.8 ± 11.8 | 71.3 ± 30.4 |
| NT21 | 52.5 ± 7.8 | 72.3 ± 29.6 |
| NT76ia | 52.1 ± 12.3 | 61.1 ± 25.8 |
| 138id | 55.4 ± 12.4 * | 64.7 ± 29.6 |
| 113id | 56.9 ± 9 ** | 59.1 ± 23.8 |
| NT134ia | 60.5 ± 5.4 *** | 78.0 ± 19.7 ** |
| 108ia | 53.8 ± 7.8 | 58.0 ± 22.1 |
| NT88 | 56.6 ± 9 ** | 59.1 ± 21.9 |
| 131id | 53.1 ± 6.7 | 66.8 ± 20.4 |
| NT76ie | 56.1 ± 4.5 * | 61.4 ± 23.7 |
| 108ic | 51.1 ± 4.9 | 57.9 ± 22.7 |
| 125ib | 56.9 ± 8.7 ** | 72.9 ± 14.5 * |
| 140ic | 52.6 ± 8.7 | 58.5 ± 23.1 |
| Treatments | Shoot Height (cm) | Shoot Biomass (g) |
|---|---|---|
| Control | 60.2 ± 5.7 | 76.1 ± 20.4 |
| 115ic | 59.7 ± 11.1 | 81.1 ± 22.2 |
| 3 | 55.1 ± 11.2 | 70.7 ± 19.7 |
| NT158 | 58.7 ± 13.8 | 69.3 ± 16.5 |
| NT21 | 55.6 ± 9.2 | 74.6 ± 22.7 |
| NT76ia | 59.4 ± 9.9 | 69.2 ± 24.4 |
| 138id | 64.3 ± 4.3 | 85.1 ± 18.8 |
| 113id | 61.7 ± 5.5 | 84.0 ± 20.8 |
| NT134ia | 69.1 ± 7.9 *** | 90.9 ± 17.2 * |
| 108ia | 67.6 ± 4.8 ** | 89.5 ± 13.2 * |
| NT88 | 66.8 ± 3.3 * | 95.3 ± 12.2 ** |
| 131id | 59.4 ± 9.2 | 88.5 ± 29.2 * |
| NT76ie | 59.7 ± 6.1 | 78.8 ± 24.5 |
| 108ic | 60.5 ± 8.4 | 79.6 ± 19.5 |
| 125ib | 59.2 ± 9.7 | 77.5 ± 17.8 |
| 140ic | 60.2 ± 11.1 | 89.5 ± 26.7 * |
Publisher’s Note: MDPI stays neutral with regard to jurisdictional claims in published maps and institutional affiliations. |
© 2020 by the authors. Licensee MDPI, Basel, Switzerland. This article is an open access article distributed under the terms and conditions of the Creative Commons Attribution (CC BY) license (http://creativecommons.org/licenses/by/4.0/).
Share and Cite
Tokgöz, S.; Lakshman, D.K.; Ghozlan, M.H.; Pinar, H.; Roberts, D.P.; Mitra, A. Soybean Nodule-Associated Non-Rhizobial Bacteria Inhibit Plant Pathogens and Induce Growth Promotion in Tomato. Plants 2020, 9, 1494. https://doi.org/10.3390/plants9111494
Tokgöz S, Lakshman DK, Ghozlan MH, Pinar H, Roberts DP, Mitra A. Soybean Nodule-Associated Non-Rhizobial Bacteria Inhibit Plant Pathogens and Induce Growth Promotion in Tomato. Plants. 2020; 9(11):1494. https://doi.org/10.3390/plants9111494
Chicago/Turabian StyleTokgöz, Serkan, Dilip K. Lakshman, Mahmoud H. Ghozlan, Hasan Pinar, Daniel P. Roberts, and Amitava Mitra. 2020. "Soybean Nodule-Associated Non-Rhizobial Bacteria Inhibit Plant Pathogens and Induce Growth Promotion in Tomato" Plants 9, no. 11: 1494. https://doi.org/10.3390/plants9111494
APA StyleTokgöz, S., Lakshman, D. K., Ghozlan, M. H., Pinar, H., Roberts, D. P., & Mitra, A. (2020). Soybean Nodule-Associated Non-Rhizobial Bacteria Inhibit Plant Pathogens and Induce Growth Promotion in Tomato. Plants, 9(11), 1494. https://doi.org/10.3390/plants9111494

